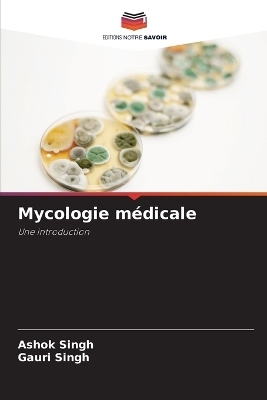
Mycologie m&eacute;dicale - Ashok Singh, Gauri Singh

Mycologie médicale
Seiten
2024
Editions Notre Savoir (Verlag)
978-620-7-39541-5 (ISBN)
Editions Notre Savoir (Verlag)
978-620-7-39541-5 (ISBN)
- Keine Verlagsinformationen verfügbar
- Artikel merken
La mycologie médicale fait référence à l'étude des champignons qui produisent des maladies chez les humains et d'autres animaux. Les champignons sont des micro-organismes eucaryotes. Les champignons peuvent se présenter sous forme de levures, de moisissures ou sous une combinaison des deux formes. Ces notes fournissent aux étudiants les dernières informations sur les infections fongiques, en commençant par un aperçu général expliquant les caractères généraux, la morphologie, la classification des champignons et des maladies fongiques et la reproduction des champignons. D'autres chapitres couvrent les différentes catégories d'infections fongiques, notamment les mycoses cutanées superficielles, les mycoses sous-cutanées, les mycoses systémiques, les mycoses opportunistes et les infections fongiques des yeux et des oreilles. Pour chacune des maladies fongiques médicalement importantes, nous avons tenté d'intégrer les aspects fondamentaux de la mycologie avec une compréhension des caractéristiques morphologiques et culturelles, de la pathogenèse de l'infection, des caractéristiques cliniques, du diagnostic en laboratoire et du traitement des maladies fongiques. Nous demandons et invitons également nos étudiants à envoyer leurs précieux conseils et critiques pour améliorer davantage ce livre.
Le Dr Ashok Singh travaille actuellement en tant que professeur agrégé au Département de microbiologie Dolphin (PG) de l'Institut des sciences biomédicales et naturelles, Dehradun, Uttarakhand, Inde. Il a obtenu son doctorat. diplôme de l'Université centrale HNB Garhwal, Srinagar Garhwal, Inde.
| Erscheinungsdatum | 21.04.2024 |
|---|---|
| Sprache | französisch |
| Maße | 152 x 229 mm |
| Gewicht | 131 g |
| Themenwelt | Naturwissenschaften ► Biologie ► Allgemeines / Lexika |
| Naturwissenschaften ► Biologie ► Mikrobiologie / Immunologie | |
| Schlagworte | infections fongiques • Microbiologie • Mycologie |
| ISBN-10 | 620-7-39541-7 / 6207395417 |
| ISBN-13 | 978-620-7-39541-5 / 9786207395415 |
| Zustand | Neuware |
| Informationen gemäß Produktsicherheitsverordnung (GPSR) | |
| Haben Sie eine Frage zum Produkt? |
Mehr entdecken
aus dem Bereich
aus dem Bereich
Buch | Softcover (2024)
Wiley-VCH (Verlag)
CHF 55,85
Band 2: Elektrizität, Optik und Wellen
Buch | Softcover (2022)
Wiley-VCH (Verlag)
CHF 55,85
Vom Ursprung der Sexualitat zum modernen Menschen
Buch | Softcover (2025)
UTB (Verlag)
CHF 54,60


